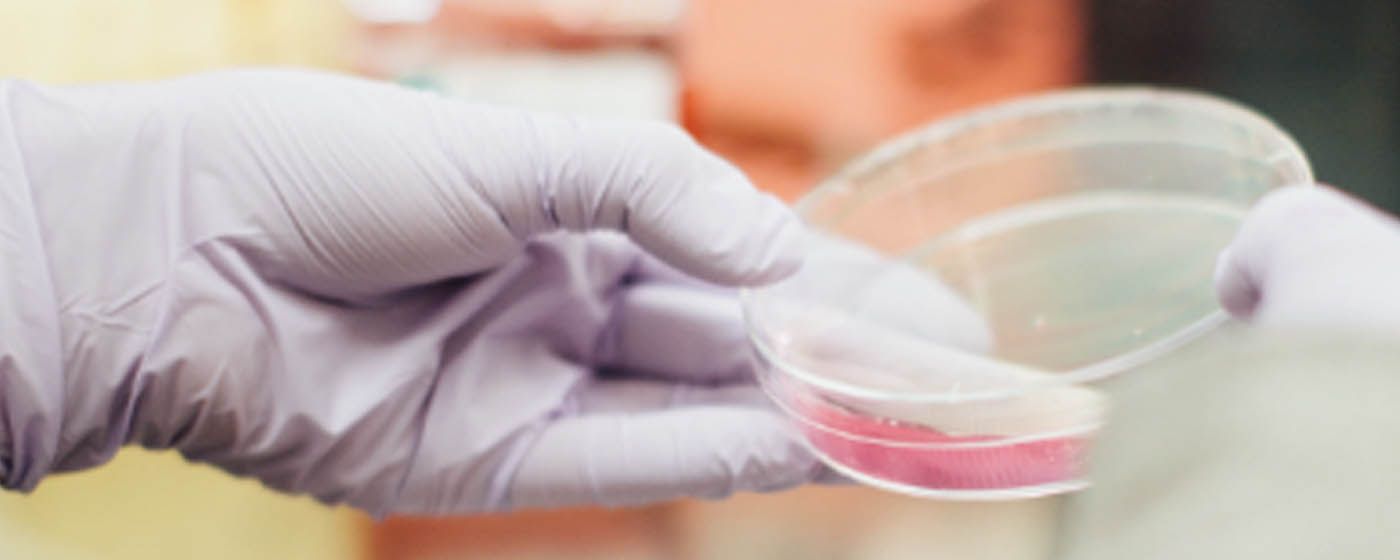
index.php?option=com_content&view=article&id=28538&catid=136&Itemid=1382

Cogit oraz Taxilla rozpoczynają współpracę w zakresie e-fakturowania do KSeF
Od początku 2022 r. w Polsce funkcjonuje Krajowy System e-Faktur (KSeF). Rozwiązanie ma obsługiwać do nawet ponad 2 mld faktur miesięcznie. Na razie korzystanie z KSeF jest dobrowolne, ale stanie się obligatoryjne począwszy od II kwartału 2023 r. Resort finansów przygotował już interfejs programowania (API), który pozwala na integrację zewnętrznych programów księgowych z systemem.
Grupa Kapitałowa GPW wybrała Cogit jako dostawcę centralnego systemu controllingowego
Cogit wyposaży Giełdę Papierów Wartościowych w Warszawie S.A. w centralny system controllingowy. Przedmiotem współpracy jest kompleksowe zaprojektowanie, parametryzacja i dostosowanie systemu, a także jego utrzymanie i rozwój we wszystkich spółkach Grupy Kapitałowej GPW. Wdrożenie będzie bazowało na wersji chmurowej Infor d/EPM, systemu Performance Management, który stanowi pełne wsparcie controllingu w zakresie budżetowania, analiz, raportowania oraz konsolidacji finansowej.
Chmura na wyciągnięcie ręki
Chmura jest jednym z najszybciej rozwijających się i najbardziej perspektywicznych segmentów rynku IT. Nic dziwnego, bo przetwarzamy coraz większą ilość danych, nie tylko tych wewnętrznych, ale też z zewnątrz firmy. Jednak w kwestii adopcji usług chmurowych polskie przedsiębiorstwa mają wciąż wiele do zrobienia.
Narzędzia wspierające ochronę sygnalistów w Polsce
Minimalne wymogi i standardy dotyczące ochrony sygnalistów zostały wprowadzone do prawa wspólnotowego w 2019 r., natomiast pierwsze polskie firmy będą musiały się podporządkować nowym regulacjom już 17 grudnia 2021 r. Z pomocą przychodzą im systemy whistleblowingowe, które pomagają w bezpieczny sposób zgłaszać nieprawidłowości i ewidencjonować zgłoszenia.
Codec Polska wdraża rozwiązanie controllingowe w ITP S.A
ITP SA specjalizuje się w selekcji najlepszych technologii i światowych marek w zakresie medycyny estetycznej, urządzeń medycznych i sprzętu wellness. Wdrożony system ma wspierać dynamiczny rozwój firmy i idący za tym wzrost potrzeb informacyjnych.
Usługi Codec Polska będą dostępne w Chmurze Krajowej
Codec Polska i Operator Chmury Krajowej rozpoczęły współpracę w obszarze usług Business Intelligence, rozwiązań dla controllingu i konsolidacji finansowej świadczonych za pośrednictwem infrastruktury Chmury Krajowej.
CDP automatyzuje procesy planowania sprzedaży i budżetowania
Wzrost szybkości planowania, wyeliminowanie błędów związanych z wykorzystaniem Excela, łatwiejsze wprowadzanie zmian oraz ich natychmiastowa wizualizacja, to tylko wybrane elementy, które przyczyniły się do usprawnienia procesu planowania sprzedaży oraz dystrybucji nowych gier.
Codec z nową indentyfikacją wizualną
Grupa Codec odświeża swoją markę, wprowadzając nowe logo i identyfikację wizualną. Zmiana ma na celu wprowadzenie spójnego przekazu oraz wizualizacji w ramach całej grupy w Europie.
Nowy system do controllingu w Banku Polskiej Spółdzielczości
Bank BPS wraz z Codec Polska poprowadzi wdrożenie nowego systemu budżetowego bazującego na technologii firmy Infor. Oprócz wsparcia procesów planistycznych, rozwiązanie pozwoli zwiększyć Bankowi efektywność w obszarze analityki i raportowania, dzięki wykorzystaniu zaawansowanych możliwości Business Intelligence. Jest to już kolejne wdrożenie Codec w instytucji finansowej w Polsce.
Leroy Merlin z systemem do controllingu wdrożonym przez Codec
Codec Polska wdrożył system wspierający realizację procesów budżetowania, analiz i raportowania w Leroy Merlin Polska. Rozwiązanie pozwoliło zwiększyć efektywność w obszarze controllingu oraz dostosować ją do standardów ADEO, w którego skład wchodzi Leroy Merlin Polska oraz ponad 30 przedsiębiorstw z 12 krajów na świecie.
PKO Bank Polskiusprawnia procesy budżetowania i planowania
Firma Codec wdrożyła system informatyczny, wspierający procesy budżetowania, prognozowania i monitorowania wykonania planu w PKO Banku Polskim oraz w Grupie Kapitałowej PKO. Rozwiązanie w znaczący sposób usprawnia procesy, równocześnie umożliwiając użytkownikom biznesowym przeprowadzanie skomplikowanych analiz bez wsparcia działów IT.
BZK Group sp. z o.o. wdraża controlling na bazie rozwiązania Oracle
Firma Codec Systems wdrożyła system kontrolingowy oparty na produktach Oracle w Grupie BZK Group. Wdrożony system - Oracle Hyperion Planning - odpowiada za planowanie, prognozowanie sprzedaży, raportowanie oraz analizy biznesowe w spółkach Komagra sp. z o.o., Bioagra S.A., Bioagra-Oil S.A. oraz BZK Group sp. z o.o.
Centralny system controllingowy w GK LPP SA
Codec Systems zakończył prace związane z wdrożeniem centralnego systemu controllingowego (Corporate Management System) w Grupie Kapitałowej LPP S.A.
MPC objął już całą strukturę PKO BP
Codec Systems zakończył kolejny etap wdrożenia systemu controllingowego MPC w Banku PKO BP. Projekt udoskonalił procesy budżetowania oraz możliwości bieżącej weryfikacji wykonania planów przez bank. Obecnie system obejmuje ponad 600 samodzielnych oddziałów PKO BP.
Prognozowanie biznesu z Codec Systems
Codec Systems, producent systemów klasy Business Intelligence, wprowadza na polski rynek własny system do prognozowania wyników działalności firm. Codec Scenario Planner (CSP) ma wspomagać podejmowanie decyzji zarządczych na podstawie informacji o planowanych w firmie inicjatyw oraz ich prognozowanego wpływu na rozwój przedsiębiorstwa.
Controlling w 600 oddziałach PKO BP
Informatyczna firma Codec Systems rozszerza zasięg centralnego systemu do controllingu w banku PKO BP. Poza centralą system MPC obsługiwać będzie 600 oddziałów banku. W przyszłym roku system obsłuży ponad tysiąc oddziałów.
Codec Systems wsparł controlling w ING Banku Śląskim
Codec Systems wdrożył w ING Banku Śląskim rozwiązanie klasy Business Intelligence MPC, które odpowiada za organizację procesów budżetowania w centrali banku. Uruchomiony model biznesowy zawiera w sobie biznesową logikę centralnego budżetowania banku.
Codec wdraża Business Intelligence zagranicą
Obecnie polski oddział irlandzkiej firmy informatycznej Codec Systems prowadzi zagranicą pięć równoległych prac wdrożeniowych. Projekty pozyskała centrala w Irlandii, jednak Polacy mają duży udział w zakresie przygotowywania parametrów systemów informatycznych klasy Business Intelligence do pracy w nowych organizacjach.
Codec System wdaża controlling w BRE Banku
Polski oddział irlandzkiej firmy Codec Systems prowadzi prace wdrożeniowe systemu informatycznego MPC w grupie BRE. Rozwiązania będą wspomagać prowadzenie controllingu grupy, obejmując wszystkie jednostki organizacyjne BRE.
Business Intelligence od Codec Systems przebadany
Firma analityczna Bloor Research poddała badaniom system informatyczny Inflection Point. Wyniki analizy dowodzą, że autorskie rozwiązanie firmy Codec Systems usprawnia procesy decyzyjne na wszystkich poziomach organizacji. Inflection Point należy do klasy systemów Business Intelligence. W pracach projektowych tego rozwiązania kluczową rolę pełnili konsultanci i inżynierowie-informatycy z polskiego oddziału firmy Codec Systems